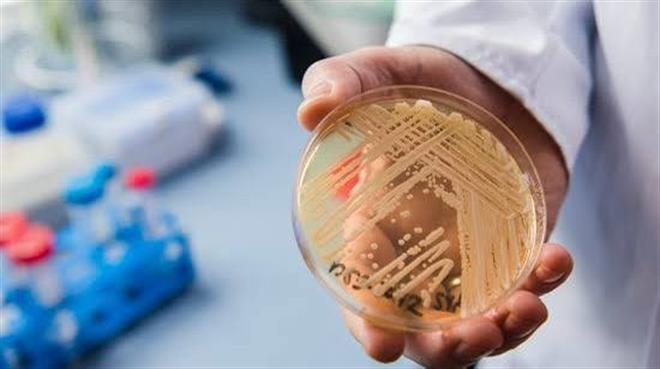

هۆشداری لە بڵاوبوونەوەی کەڕوویەکی کوشندە و بەرگریکار بەرامبەر دەرمان لە نەخۆشخانەکانی جیهاندا
وێستگە ستایل-
هۆشداری لە بڵاوبوونەوەی کەڕوویەکی کوشندە و بەرگریکار بەرامبەر دەرمان لە نەخۆشخانەکانی جیهاندا
وێستگە ستایل - سۆلین عوسمان
پێداچوونەوەیەکی زانستی نوێ کە ئەمڕۆ دووشەممە بڵاوکراوەتەوە، هۆشدارییەکی توند دەدات لەبارەی بڵاوبوونەوەی خێرای جۆرە کەڕوویەکی مەترسیدار بە ناوی (Candida auris). ئەم میکرۆبە کە بەرگرییەکی سەرسوڕهێنەری بەرامبەر دەرمانە دژەکەڕووەکان هەیە، تا ئێستا لە زیاتر لە ٦٠ وڵاتی جیهاندا دەستنیشان کراوە و بە شێوەیەکی مەترسیدار لەناو ژینگەی نەخۆشخانەکاندا، بەتایبەتی لە ئەمریکا و ئەوروپا، لە گەشەکردندایە و بووەتە ئاستەنگێکی گەورە بۆ تیمی پزیشکی.
زاناکان و پسپۆڕانی نەخۆشییە گوازراوەکان دەڵێن ئەم کەڕووە توانایەکی زۆری هەیە بۆ مانەوە لەسەر پێستی مرۆڤ و ڕووە ڕەقەکان بۆ ماوەیەکی زۆر، ئەمەش وایکردووە کۆنتڕۆڵکردنی لە ناوەندە تەندروستییەکاندا زۆر قورس بێت. تەنها لە ساڵی ٢٠٢٥دا، نەخۆشخانەکانی ئەمریکا نزیکەی ٧٠٠٠ حاڵەتی تووشبوونیان تۆمار کردووە، کە زۆربەیان ئەو نەخۆشانەن کە لەژێر چاودێری ورددان یان ئامێری هەناسەدانی دەستکردیان بۆ بەکارهێنراوە، ئەمەش مەترسی گیانلەدەستدانی بۆ ئەو کەسانە بە ڕێژەیەکی بەرچاو زیاد کردووە.
بڵاوبوونەوەی ئەم کەڕووە لە بەشەکانی چاودێری ورد (ICU) و ناوەندەکانی چاودێری درێژخایەن، سیستمی تەندروستی وڵاتە پێشکەوتووەکانیشی تووشی کێشە کردووە. چونکە (C. auris) نەک هەر بە ئاسانی دەگوازرێتەوە، بەڵکو بەرگری بەرامبەر زۆربەی ئەو دەرمانانە پەیدا کردووە کە پێشتر بۆ لەناوبردنی کەڕوو بەکاردەهاتن، ئەمەش بژاردەکانی چارەسەری بەردەم پزیشکانی زۆر کەم کردووەتەوە و وایکردووە هەندێک لە حاڵەتەکان بە تەواوی بێ چارەسەر بمێننەوە.
پزیشکان ڕوونی دەکەنەوە کە هەرچەندە کەسانی تەندروست مەترسییەکی کەمیان لەسەرە، بەڵام بەساڵاچووان و ئەو کەسانەی سیستمی بەرگری جەستەیان لاوازە لەبەردەم هەڕەشەیەکی ڕاستەقینەدان. بەهۆی کەمی ئامێرەکانی دەستنیشانکردنی خێرا و نەبوونی دەرمانی نوێ لەم بوارەدا، زاناکان داوا دەکەن بە پەلە بودجەی توێژینەوە بۆ دۆزینەوەی ڤاکسین و ڕێگەی نوێی چارەسەر تەرخان بکرێت پێش ئەوەی بارودۆخەکە لە کۆنتڕۆڵ دەربچێت.
یەکێک لە دۆزینەوە هیوابەخشەکان لەلایەن توێژەرانی زانکۆی "ئێکستەر"ەوە ئەوەیە کە ئەم کەڕووە بۆ گەشەکردنی زۆر پشت بە ماددەی ئاسن دەبەستێت لە ناو جەستەدا. ئەم تێگەیشتنە نوێیە ڕێگە خۆش دەکات بۆ دروستکردنی چارەسەری ورد کە ڕاستەوخۆ کار لەسەر ئەو خاڵە لاوازەی کەڕووەکە بکات و ڕێگری لە گەشەکردنی بگرێت. لە ئێستادا تەنها ڕێگە بۆ ڕێگریکردن لە بڵاوبوونەوەی، گرتنەبەری ڕێوشوێنی توندی پاکژکردنەوە، چاودێری وردی نەخۆشخانەکان و هەماهەنگی نێودەوڵەتییە.
سەرچاوە: گۆڕانکارییە زانستییەکانی زانکۆی ئێکستەر و ڕێکخراوی تەندروستی جیهانی
AM:12:31:06/01/2026
ئهم بابهته 652
جار خوێنراوهتهوه